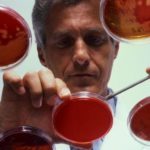
Липиды крови норма у женщин по возрасту таблица - Про холестерин

Наше здоровье во многом зависит от химического состава крови. Его изменение провоцирует разные рецидивы, требующие госпитализации. С каждым прожитым годом все капризнее ведет себя холестерин – природный жирный спирт.
Уровень липидов меняется по многим причинам. Для женщин, к примеру, норма будет зависеть от возраста, женских и эндокринных болезней, беременности, наследственности, иммунитета.
Актульная информация: норма холестерина в крови.
«Плохой» и «хороший» холестерин
Органическое жироподобное соединение играет в теле жизненно обеспечивающую функцию, способствующую обновлению эпителия кожи и органов.
- Оно, как цемент, поддерживает клеточный каркас;
- Встраиваясь в мембрану, увеличивает плотность и делает ее жесткой;
- На холестериновой основе синтезируются прогестерон, андрогены, эстроген, тестостерон и другие гормоны;
- Грудничок для своего развития получает холестерин из грудного молока;
- Холестерин – важный компонент желчи, помогающей усваивать жиры, а, значит, и холестерин;
- Пищевое соединение помогает поддерживать в норме слизистую кишечника;
- Витамин Д, используемый для роста, поддержки иммунитета, синтеза инсулина, стероидных гормонов, вырабатывается из холестерина с помощью солнечного света.
В почках, печени, надпочечниках, кишечнике образуется 80% холестерина. Еще 20% организм получает с пищей. В воде вещество не растворяется, поэтому с кровью оно доставляется вместе с белками, образующими растворимую форму. Такая субстанция получила название липопротеидов.
Различают несколько классов липопротеидов: с низкой плотностью, очень низкой, высокой, триглицериды, хиломикроны.
Каждая разновидность выполняет свою функцию. ЛПНП нерастворимы, поэтому часто выпадают в осадок и образуют в сосудах уплотнения, повышающие риск появления атеросклероза. В обиходе они получили название «плохого» холестерина. ЛПВП транспортируют холестерин в печень, откуда излишки и выводятся из организма.
Этот класс липопротеидов не обладает атерогенным эффектом, поэтому их называют «хорошим» холестерином. Навешивание ярлыков не значит, что первый тип приносит телу только вред, а другой работает с пользой.
Низкая плотность липопротеидов опасна тем, что они не всегда достигают цели (транспортировка холестерина в клетку) и оседают в сосудистом русле в виде плотных бляшек. Высокая плотность – гарантия не только правильной транспортировки, но и возможности удаления части накопившихся холестериновых бляшек.
Если ЛПНП можно рассматривать как снабженцев, то ЛПВП играют роль регулировщиков, контролирующих избыток холестерина. Если наступает разлад, и первый тип липопротеидов доминирует, подавляя активность второго, биохимический анализ показывает повышенный холестерин.
Эти особенности должен знать не только доктор – экстренные меры приходится принимать именно пациенткам.
Холестерин: норма у женщин по возрасту
Ученые Бостонского Университета изучали, как холестерин воздействует на умственную деятельность. Из 1894 добровольцев, принимавших участие в эксперименте, большинство были женщины.
Результаты испытаний показали, что участники, у которых был относительно высокий холестерин, преодолевали интеллектуальные нагрузки эффективнее на 49% по сравнению с теми, у кого были отмечены низкие показатели.
В итоге у многих сложилось впечатление о том, что повышенное содержание холестерина – это хорошо. А как обстоят дела в действительности?
Жизни без холестерина нет, но когда его концентрация переходит определенный барьер, он расслаивает стенки и забивает сосуды. Когда там возникает тромб, это грозит инсультом, инфарктом миокарда или гангреной конечности.
Будет холестерин переносить жир в сосуд или из сосуда, зависит от показателей, которые доктор изучает в общей холестериновой формуле. Норма общего холестерина – 5,5 ммоль/л. Для триглицеридов (ТГ) у женщин ориентиром случит показатель 1,5 ммоль/л, у мужчин – до 2-х ммоль/л. Жиры, накапливаемые организмом, (чаще всего – на талии) служат источником энергии для мышечных клеток.
Если они не сжигаются, развивается ожирение. Куда тащит жир эта транспортная молекула, именуемая холестерином? Это зависит от двух параметров: «плохой» холестерин – ЛПНП и «хороший» – ЛПВП. Соотношение всех этих компонентов подсчитывается при выявлении вероятности развития атеросклероза.
Концентрация липидов – важный показатель оценки состояния здоровья. Этот критерий не статичен: то, что в молодости можно было считать нормой, с возрастом уже не устраивает. Корректируют норму и разные заболевания (гипертония, сахарный диабет и т.п.). Поэтому медики и разработали для ориентира возрастные нормы ЛПНП и ЛПВП.
- Понимание этих процессов поможет предотвратить тяжелые болезни.
- Если проанализировать данные, демонстрирующие холестерин в норме у женщин по возрасту в таблице (общий показатель – это сумма значений ЛПНП и ЛПВП), можно увидеть, что диапазон холестериновой нормы изменяется с возрастом.
Для контроля химического состава надо регулярно сдавать кровь для биохимических исследований. Для женщин, старше 35 лет, контролировать показатели надо раз в 2 года.
Все, кто находится в группе риска, проходят обследование ежегодно. Обследование проводят натощак (8 часов без еды).
При наличии сопутствующих заболеваний эндокринной системы в течение 2-х дней перед забором крови из вены надо соблюдать диету, избегать стрессов. Даже при соблюдении всех условий медики иногда предлагают повторить биохимический анализ через 2 месяца.
Некоторые возрастные особенности допустимого диапазона у женщин после /40 / 50 / 60/ лет:
- До 30 лет значения ЛПВП и ЛПНП у девушек, как правило, низкие, так как ускоренный метаболизм прекрасно справляется с липидами даже при неправильном питании. Корректируют норму патологические факторы: высокий уровень глюкозы в крови, почечная недостаточность, повышенное давление. Ориентировочный критерий: общий холестерин – 5,75 ммоль/л, ЛПВП – 2,15 ммоль/л, ЛПНП – 4,26.
- После 40-ка нормальным считается общий холестерин в пределах 3,9-6,6 ммоль/л. Для липопротеидов низкой плотности – 1,9-4,5 ммоль/л, высокой – 0,89-2,29 ммоль/л. Это примерный ориентир, в реальности медики оценивают состояние здоровья и по другим результатам анализов. Курение, обезжиренные диеты могут повысить эти показатели, так как обменные процессы будут менее активными.
- После 50-ти изменение концентрации холестерина обусловлено уменьшением проницаемости и эластичности сосудов, сердечными и другими заболеваниями. В общем случае допускается 4,3-7,5 ммоль/л. после спада репродуктивной функции снижается концентрация эстрогенов, защищающих женщин от перепадов уровня липидов.
- После 60 лет учитываются не только стандартные показатели, но и наличие хронических болезней. Повышает концентрацию «вредного» холестерина и менопауза. В этом возрасте важно регулярно контролировать также уровень сахара и давления. Все, что выходит за рамки 4,45-7,7 ммоль/л, корректируется медикаментами и диетой. Для ЛВПП и ЛПНП нормы в этом возрасте – 0,98-2,38 ммоль/л и 2,6-5,8 ммоль/л соответственно.
- После 70 концентрация липидов в норме должна понижаться. Если ваши показатели не укладываются в рекомендуемый диапазон, это должно быть поводом для обследования. Возрастные параметры для женщин этой возрастной категории: до 2,38 ммоль/л «хороший», до 5,34 ммоль/л «плохой» и до 7,35 ммоль/л – общий холестерин.
Холестерин в крови, норму у женщин по возрасту, удобно сравнивать в таблице.
| Возраст, лет | Общий холестерин, ммоль/л | ЛПНП, ммоль/л | ЛПВП, ммоль/л |
| 20-25 | 3,16-5,6 | 1.48-4,12 | 0,95-2,04 |
| 30-35 | 3,37-5,96 | 1,81-4,04 | 0,93-1,99 |
| 40-45 | 3,81-6,53 | 1,92-4,51 | 0,88-2,28 |
| 50-55 | 4,2-7,4 | 2,28-5,21 | 0,96-2,35 |
| 60-65 | 4,45-7,7 | 2,6-5,8 | 0,98-2,38 |
| От 70 | 4,48-7,25 | 2,28-5,21 | 0,85-2,38 |
Склонность к повышенному холестерину у женщин может носить наследственный характер. До менопаузы инсульты и инфаркты женщинам не страшны, так как концентрация ЛПВП у них выше, чем у мужчин.
Так как границы климактерического периода индивидуальны (как и особенности его проявления), важно в этот период контролировать все жизненно важные параметры, включая жировой обмен в крови.
О чем говорят анализы на холестерин (норма у женщин), можно узнать из передачи «Жить здорово», где их комментирует профессор Е. Малышева.
Норма холестерина для беременных
Химический состав крови у будущих мам имеет свои особенности, связанные с удвоенным кровоснабжением, весовой категорией, возрастом, дополнительной нагрузкой на организм.
В 25-30 лет в первом триместре беременности нормальным считается диапазон от 3,3 до 5,8 ммоль/л. В дальнейшем концентрация триглицеридов удваивается.
У беременных старше 40 лет нормальный холестерин близок к отметке 7 ммоль/л. С увеличением срока беременности анализ крови на холестерин нормы меняет, так как его показатели также будут расти.
Указанные стандарты можно воспринимать только как ориентировочные, так как концентрация липидов изменяется под влиянием провоцирующих факторов.
Симптомы отклонений от нормы
Признаки нарушений состояния сосудов проявляются тогда, когда стрессы, высокое АД, неадекватные нагрузки провоцируют появление тромбов, разрывов, сужение сосудов. Нарушение кровотока головного мозга проявляется бессонницей, головными болями, проблемами с координацией, потерей памяти. Со временем клетки отмирают, провоцируя слабоумие.
Если есть проблемы с венами ног, признаками формирования утолщений будут боли и судороги мышц (особенно при ходьбе), онемение пальцев, изменение температуры конечностей и цвета кожных покровов.
Со временем боли усиливаются даже в горизонтальном положении, на коже возникают трофические язвы. Если процесс не остановить, возможна ампутация конечности.
На лице признаки холестериновых бляшек можно увидеть на глазах в виде желтоватых пятен и уплотнений на веках. Устранение косметических дефектов хирургическими методами не гарантирует исцеления без комплексного лечения проблемы.
Как скорректировать повышенный холестерин
Как правило, обследования нарушений липидного обмена диагностируют у женщин именно повышенные показатели, так как низкая концентрация – редкое явление. Обусловлено оно несколькими причинами:
- Дисбалансом рациона при отказе от жиров в пользу углеводов;
- Проблемами щитовидной железы;
- Серьезными патологиями печени;
- Систематическим недоеданием при полном отсутствии жиров в рационе;
- Повышенным стрессовым фоном.
Повышают концентрацию холестерина многие факторы. Так как с пищей в организм поступает только 20% холестерина, решающего воздействия на его повышение рацион питания не оказывает, если, конечно, не кидаться в крайности. Прежде всего, надо уделить внимание своей физической форме, нормализовать вес, контролировать эмоции.
Если этих мер недостаточно (генетическая предрасположенность, сахарный диабет, гипертония, атеросклероз и другие заболевания, провоцирующие образование холестериновых бляшек), надо обращаться за медицинской помощью.
Выбор схемы лечения и диеты находится в компетенции специалистов, так как бесконтрольный прием таких серьезных препаратов может способствовать накоплению побочных эффектов. Чрезмерное понижение холестерина не менее опасно, чем его повышение.
Особенно следует проявлять осторожность пациентам зрелого возраста: к примеру, фибраты могут провоцировать нарушения функций ЖКТ.
Процесс восстановления длительный, часто лекарства и диету приходится соблюдать пожизненно. Разработаны разные методы нормализации ЛПВП и ЛПНП:
- Медикаментозное лечение – назначают статины, фибраты, никотиновую кислоту, пробукол;
- Изменение пищевых привычек в сторону стабилизации жиров;
- Борьба с ожирением, нормализация функций ЖКТ;
- Применение методов альтернативной медицины;
- Активный образ жизни.
Фитотерапия зарекомендовала себя как надежный способ нормализации холестерина. С этой целью используют настои цветков липы, корней одуванчика, семени льна.
Рыбный жир Имбирь Чеснок Корица Фреш Зеленый чай
Полезно употреблять фреш из яблок, моркови и огурцов, взятых в равных пропорциях. По стакану сока надо выпивать каждый день в течение недели.
Аналогичными возможностями обладают виноградные, грушевые, ананасные соки. Полкило сырых овощей и фруктов ежедневно безопасно чистят сосуды, нормализуют обменные процессы.
Диетологи добавляют к этим рекомендациям зеленый чай, рыбный жир, чеснок, корицу, имбирь, куркуму. Ухудшает показатели уменьшение кратности приема пищи (менее 3-х раз в день). Следует следить также за своевременным освобождением кишечника.
Мнение эксперта о том, как нормализовать холестерин, смотрите на этом видео
Экспериментально установлено, что норма холестерина – критерий динамичный. Он зависит от возраста, гормонального фона, патологий эндокринной системы. Норма ЛПВП и ЛПНП для 60-летних женщин выглядит как повышенная для 30-тилетних девушек.
Существенно влияют на жировой обмен беременность и климакс. Чем дольше активны половые гормоны, тем лучше показатели проблемного соединения.
Качественный состав крови зависит как от общего холестерина, так и от пропорций «плохого» и «хорошего». Внимания заслуживает постоянство содержания ЛПВП. Его значение в норме не меняется с течением лет. Контроль своих показателей (липидограмма) поможет предупредить сосудистые патологии с тяжелыми осложнениями.
Норма холестерина по возрасту и полу [наглядная таблица]
Бытует мнение, что холестерин – это вредное соединение, которое может расшатать здоровье сердечно-сосудистой системы, вплоть до самых тяжелых осложнений – атеросклероза, инфарктов и инсультов.
Действительно, при нарушенном липидном обмене, когда показатели холестерина значительно превышают нормальные, такие последствия возможны.
Зная об этом, каждый человек задается вопросом, высокий уровень – это сколько?
Подробно рассмотрим, какая норма холестерина в крови по возрасту и полу считается безопасной. Приведем официальные таблицы значений от сертифицированных лабораторий.
Почему нужно следить за уровнем холестерина
В норме, холестерол – это не просто составная часть метаболизма, а жизненно необходимое вещество. По своей структуре, он является сложным жироподобным спиртом. Порядка 20% общего количества холестерина – экзогенного происхождения, то есть поступающего в организм с пищей. Остальной, эндогенный, синтезируется внутренними органами, в первую очередь – печенью и кишечником.
Холестерин принимает участие почти во всех процессах биосинтеза стероидных и половых гормонов, поскольку является для них субстратом. Кроме того, он является строительным материалом для клеточных стенок и мембран, участвует в трансформации витамина Д.
Сам по себе, холестерин – неподвижное соединение, поэтому для того, чтобы транспортироваться в органы и клетки-мишени, он связывается с «белками-переносчиками». Полученный молекулярный конгломерат называется липопротеидом.
Они бывают трех видов – ЛПВП, ЛПНП и ЛПОНП (высокой, низкой и очень низкой плотности соответственно).
У здорового взрослого человека должны быть все эти фракции, но в пределах конкретных норм и определенной пропорцией между друг другом.
Липопротеиды низкой плотности, условно принято именовать «плохим» холестеролом, а ЛПВП – «хорошим». Связано это с особенностью их свойств. Жиры низкой плотности легче, мельче и обладают способностью прилипать друг к другу и к стенкам артерий.
Таким образом, когда возрастает их содержание в крови, они начинают оседать между волокнами эндотелия, вызываю в нем воспалительные процессы. Впоследствии, в таких очагах формируются атеросклеротические бляшки.
Свою роль ЛПНП играют и в процессе тромбообразования, ведь они склеиваются не только друг с другом, но и с другими крупными клетками крови.
Избыточный холестерин может откладываться в сосудах
Этот механизм лежит в основе такого заболевания, как атеросклероз сосудов. Процесс повышения концентрации вредного холестерина не отображается внешне, то есть на первых этапах болезнь протекает без симптомов или каких-либо клинических признаков. На начальной стадии, распознать нарушение липидного баланса можно только в биохимическом анализе крови из вены.
Чем раньше будет диагностировано изменение нормальных значений холестерина, тем легче и быстрее получится вылечиться.
Зачастую если сдвиги липидограммы выявлены вовремя и еще не проявили себя жалобами, то проблему можно решить простой корректировкой питания.
В противном случае, если ситуация запущенная и выявлена очень поздно, то прогноз на выздоровление не такой радужный – назначается медикаментозная терапия, а в некоторых случаях и хирургическое лечение.
Липидограмма (липидный профиль, спектр) – что это за анализ?
Сводная таблица норм холестерина в крови у женщин и мужчин
Какие показания холестерина считаются нормой у здорового человека? Конкретной универсальной цифры не существует. На нее влияет множество факторов, основные из которых пол и возраст. Именно опираясь на эти два параметра, докторами составлена таблица по возрасту с показателями уровня общего холестерина в норме.
Приведенные цифры нормального уровня липидных соединений являются очень усредненными и могут отличаться индивидуально у каждого человека. Связано это с тем, что на норму холестерина влияют такие факторы, как характер питания, образ жизни, уровень физической активности, наличие вредных привычек, генетически детерминированные состояния и т. д.
Особенно опасным, в плане риска атеросклероза, является возраст после 35–40 лет. В этот период происходят гормональные перестройки организма и первые ощутимые изменения в липидограмме. К примеру, в 35 лет 6,58 единиц — это верхняя граница нормы, а в 40 лет, допустимым уровнем для мужчин общего холестерина уже считается до 6,99 ммоль/л.
Чем старше человек становится, тем больше у него появляется сопутствующих заболеваний и тем ниже становится реактивность организма. Все это добавляет дополнительный риск осложнений при липидных нарушениях.
Сахарный диабет, стенокардия, ИБС – у пожилых людей эти диагнозы встречаются довольно часто. Для них границы нормы холестерина должны быть ниже, так как компенсаторные функции сосудистой системы снижены.
Таким образом, целевой уровень при ИБС, инсультов или инфарктов в анамнезе, составляет на 2,5 ммоль/л ниже верхней границы нормы для каждого возраста соответственно.
В 50 лет отмечаются заметные изменения нормы холестерина у женщин. Связанно это со снижением синтеза гормонов, изменением их фона и снижением потребности в холестерине эндокринной системы. У мужчин после 55, а чаще – после 60 лет, показатели нормы становятся стабильными и имеют тенденцию с возрастом плавно снижаться.
При лабораторной расшифровке у взрослых, необходимо обращать внимание не только на нормы общего холестерола. Не менее важным являются значения триглицеридов, плохого и хорошего холестерина (ЛПНП и ЛПВП соответственно), коэффициента атерогенности.
Какой самый высокий холестерин может быть у человека
Согласно исследованиям, высокий холестерол – это индивидуальное понятие, поэтому нельзя сказать, какие его цифры считаются максимальными или минимальными. Показатели холестерина от 5,2 до 6,19 ммоль/л принято считать повышенными умеренно.
При таких цифрах нужно обратить внимание на другие пункты липидограммы, в особенности на ЛПНП.
Если количество общего холестерина, согласно анализу, выше 6,2 ммлоль/л, то такое состояние считается опасным для здоровья с высоким риском развития атеросклероза.
Общий холестерин больше 12 ммоль/л — на сколько это критично для жизни и что делать?
Нормы холестерола и коэффициент атерогенности
Холестерин в крови содержится в норме только в связанном виде в разных его фракциях. Эти соединения не только должны быть в определенных диапазонах нормы, но и быть в правильном соотношении между собой. Например, такой параметр в анализе, как коэффициент атерогенности, указывает на соотношении хорошего, полезного холестерола ЛПВП к показателю общего холестерина.
Коэффициент атерогенности может наиболее точно отобразить, в каком состоянии находится жировой обмен. На него обращают внимание как на индикатор гиполипидемической терапии. Для его расчета необходимо от значений общего холестерина, отнять значение полезного холестерола и полученную разницу разделить на ЛПВП.
Допустимый уровень коэффициента атерогенности соответствует определенному возрастному диапазону.
- 2,0–2, 8. Такие цифры должны быть у людей в возрасте до 30 лет.
- 3,0–3,5. Эти значения являются целевым уровнем нормы у людей старше 30, у которых нет ни лабораторных, ни клинических признаков атеросклеротического процесса.
- Выше 4. Этот показатель считается высоким. Он свойственен пациентом с диагнозом ишемической болезни сердца.
Согласно международным критериям, липидный обмен веществ приближен к норме при следующих референсных значениях:
- общий холестерол – до 5 ммоль/л,
- триглицериды – до 2,
- ЛПНП – до 3,
- ЛПВП – от 1,
- коэффициент атерогенности – до 3 единиц.
➜ Подробнее о индексе атерогенности
Нужно учитывать, что норма холестерола – залог здоровой сосудистой системы. Поэтому нужно приложить максимум усилий, чтобы стабилизировать и улучшить свой липидный профиль.
Как занятия спортом влияют на уровень холестерина?
Сделать это можно с помощью сбалансированной гипохолестериновой диетотерапией. В ней должно быть уменьшено количество животных жиров, преимущественно вареные блюда вместо жаренных, больше свежих овощей и фруктов.
Диета при повышенном холестерине хорошо сочетается с активным стилем жизни, дозированными физическими нагрузками – утренней гимнастикой, пробежками.
Когда холестерин повышен более ощутимо, то для достижения большего эффекта, доктором подбирается необходимая медикаментозная терапия, назначаются препараты из групп статинов или фибратов.
Уровень холестерола в крови – важный индикатор здоровья организма. Когда его значения начинают превышать пределы нормы, возрастает риск развития заболеваний сосудистой системы и сердца – атеросклероза, инсультов и инфарктов.
Первые стадии такого процесса не имеют внешних признаков и распознать их можно только по анализам.
Поэтому очень важно регулярно сдавать профилактические липидограммы и вовремя принимать меры, ведь чем раньше будет начато лечение, тем благоприятнее прогноз на выздоровление.
После получения результатов, следует проконсультироваться с профильным специалистом, который порекомендует необходимые меры и назначит индивидуальную терапию.
Таблицы холестерина — норма в крови у взрослых и детей (пожилых людей)
Нормы холестерина в крови по возрасту: у взрослых и детей / у молодых и пожилых людей. Расшифровка результатов биохимического анализа крови (липидограммы). Простые и наглядные таблицы: показатели уровней общего холестерина, а также (липопротеидов высокой / низкой плотности) ЛПВП, ЛПНП и ТГ (триглицеридов) / по возрасту и полу.
Рекомендации (по описаниям): нормальный уровень (все в порядке, живем и радуемся) / максимально допустимый уровень холестерина (срочно необходима профилактика / допустимо лечение народными средствами) / повышенный уровень (необходима консультация врача) / очень высокий уровень холестерина (необходимо срочное медикаментозное лечение).
Таблицы содержания холестерина:
Уровень общего холестерина
Данные цифры представлены Вашему вниманию согласно официальным рекомендациям таких авторитетных организаций, как EAS (Европейское общество по изучению Атеросклероза) и HOA (Национальное общество Атеросклероза).
Обращаем Ваше внимание на тот факт, что нормальный уровень холестерина (в зависимости от возраста и пола) – не является статической величиной. То есть, с годами он меняется. Более подробные цифры можно найти в таблице ниже.
Таблица: содержание ЛПНП холестерина
ЛПНП (LDL-С) условно «плохой» холестерол. Основная функция – защита организма от токсинов в плазме крови, «транспортировка» витамина E, каротиноидов и триглицеридов. Отрицательное качество – оседает на стенках сосудов / артерий, образуя жировые отложения (холестериновые бляшки). Создается в печени из ЛПНОП (липидов очень низкой плотности) в процессе гидролиза. В период распада имеет другое название – ЛППП, где последние буквы означают – Промежуточной Плотности.
Таблица: уровень ЛПВП — холестерина
ЛПВП (HDL-С) очень «хороший» альфа холестерин. Обладает уникальными антиатерогенными свойствами. Именно поэтому, его повышенная концентрация названа «синдромом долголетия». Данный класс липопротеинов, образно говоря, «смывает» со стенок артерий своих плохих собратьев (отправляя их обратно в печень для переработки в желчные кислоты), чем существенно снижает риски развития широкого спектра сердечно – сосудистых заболеваний и атеросклероза («тихого убийцы»).
Рекомендуемся ознакомиться: что такое коэффициент атерогенности и для чего его рассчитывают?
Таблица: содержание ТГ (триглицеридов)
Триглицериды – представляют собой органические вещества (производные глицерина), исполняющие в организме человека, самые важные структурные и энергетические функции (по сути, являясь основным компонентом клеточной мембраны, а также эффективным накопителем энергии в жировых клетках). Синтезируются в печени и поступают через пищу. Анализ на ТГ необходим для диагностики: атеросклероза (с учетом соотношения холестериновых фракций ЛПНП и ЛПВП), сахарного диабета (II Типа), острого панкреатита, «ожирения» печени, гипертиреоза, синдрома мальабсорбции и др. заболеваний. В зависимости от их пониженных или избыточных значений.
Норма холестерина в крови у детей и подростков — таблица по возрасту
- Единица измерения: ммоль/л
- Подробная статья:
- ЧТО ДЕЛАТЬ ЕСЛИ У РЕБЕНКА ПОВЫШЕН ХОЛЕСТЕРИН? ПРИЧИНЫ, ДИАГНОСТИКА И ЛЕЧЕНИЕ
Таблица — норма холестерина в крови у взрослых людей (расшифровка)
Нормы холестерина в крови у пожилых людей — таблица (по возрасту)
Полезные статьи на нашем сайте:
Выступают Юрий Никитич Беленков (врач-кардиолог, профессор, академик РАН) и Евдокименко Павел Валерьевич (практикующий врач-ревматолог, невролог, академик российской Академии Медико-Технических Наук) — очень доступно для восприятия!
Холестерин норма у женщин
- Холестерин (холестерол) играет важную роль в построении нашего организма, образуя клеточные мембраны, содержится в каждой клетке, представляя собой жироподобное (липидное) органическое соединение.
- Роль холестерина в организме:
- это кирпичики для построения нашего организма, клеток
- играет важную роль в пищеварении и формировании желчи.
- холестерин входит значительном количестве в состав молока матери, выполняя важную роль в формирование и развитие малыша.
- синтезирует разные гормоны, участвующие в формирование нашего иммунитета, обмена веществ, гормональной функции, в частности, например тестостерон, кортизон
- солнечные лучи способны превращать холестерин в витамин D под средством синтеза.
- входит в состав исключительно жиров животного происхождения.
Диета, основанная на растительной пище, хотя и понижает холестерин в крови, но не устраняет его вообще. Наш организм синтезирует холестерин примерно на 70-80% и только на 30-20% он получается из еды, которую мы употребляем в сутки.
Отказываясь полностью от жирной пищи, мы приносим один только вред организму, по крайней мере, если вы до этого часто ели богатую жирами пищу, а потом решили резко от нее отказаться.
В виду того что холестерин не растворяется в воде, а так же в крови, транспортировкой его клеткам осуществляется с помощью особого белкового соединения.
Эти белковые соединения разделяют холестерин на два вида: ЛПВП и ЛПНП. Если говорить кратко, то условно «плохой» холестерин разносится по клеткам тканей, а «хороший» выводит излишки его из организма.
Люди, садящиеся на всякие анти холестериновые диеты должны знать, что они не снижают его количества в организме, а лишь провоцируют рост плохого холестерина, при этом возможна закупорка сосудов холестериновыми бляшками.
Образование сосудистых бляшек происходит не вследствие высокого уровня холестерина в крови, а как следствие повреждение кровеносных сосудов. Холестерин используется как кирпичики для восстановления поврежденных сосудов. Важно устранять причину образования высокого уровня холестерина, а не следствие.
Хороший холестерин помогает выводить плохой из крови, предупреждая развитие артериосклероза сосудов. Появление бляшек не причина, а только следствие.
Холестерин плохой и хороший, в чем разница?
Многие люди, которые начитались научных статей и посетили множество форумов по проблеме высокого холестерина, обычно уже слышали, что такое плохой и хороший холестерин. Это определение уже стало у всех на устах.
В чем же разница между плохим холестерином и хорошим? Разницы между ними, по сути, нет. Однако как говориться, дьявол кроиться в деталях.
Дело в том, что холестерин в свободном чистом виде в организме не присутствует, а только в соединении со многими веществами. Это жиры, белки и др. элементы которые в комплексе именуют липопротеидами. Именно их состав и определяет, что считать плохим что хорошим холестерином.
Соединения из липопротеидов низкой плотности (ЛНП или ЛПНП) – это плохой. Он оседает на стенках сосудов закупоривая их, образуя бляшки. Так же действуют триглицериды (жиры), которые так же входят в соединения липопротеидов.
Хорошим холестерином можно назвать холестерин высокой плотности (ЛВП). Он транспортирует излишек обратно в печень, регулируя тем самым холестерина в крови. Его функция предупреждать атеросклероз сосудов, профилактика инсультов и инфарктов.
Как уже указывалось выше, большую часть холестерина образуется внутри самого организма, в частности в печени. Из пищеварительной системы его поступает не много не более 25%. Даже в таком виде он поступает не сразу и не весь. Сначала он всасывается в кишечнике, затем синтезируется печенью в виде желчи и потом часть его поступает обратно в пищеварительный тракт.
Диета сокращает уровень холестерина только на 9-16%
Это как вы понимаете, не решает проблему кардинально, поэтому медицина применяет лекарства, которые подавляют синтез холестерина в организме печенью. Это эффективно снижает его уровень, но не решает проблему в корне.
Норма потребления холестерина в сутки не должна превышать 300 мг. В 100 г животных жиров включает 100-110 мг холестерина.
Полезные свойства холестерина
Многие заблуждаются думая, что вся причина недуга и развития атеросклероза кроиться только в неправильном питании, богатой холестерином еде.
Здоровое питание, диета это, несомненно, плюс, но это еще не все.
Лишая организм полностью животных жиров и белков вы подвергаете свой организм испытаниям и снижению, прежде всего иммунитета, влечения, постоянному упадку сил.
Организм человека не может существовать без поступления холестерина и белков. Холестерин участвует в образовании витамина группы D, ведает за эластичность мембран клеток.
Он производит гормоны, которые непосредственно влияют на наш организм в целом, нервную систему и головной мозг.
Учитывая, что наш организм не может обходиться без холестерина важно не допускать его полного прекращения поступления, с пищей, составляя свое меню для диет. Диета обязательно должна, ограничено включать продукты содержащие жиры. Важно не то, что вы едите мясо, сладкое, жиры, а сколько вы этого едите.
Расшифровка результата анализа крови на холестерин
Общий холестерин
Общий холестерин (CHOL) в крови состоит из:
- Липопротеиды высокой плотности (ЛПВП),
- ЛПНП-холестерина
- Других липидных компонентов.
Общ. холестерин в крови должен быть не более 200 мг/дл. Более 240 мг/дл – это очень высокое значение.
Больных, у которых выявлен высокий уровень общего холестерина в крови обязательно нужно, сдавать анализы на ЛПВП, ЛПНП.
Женщинам с высоким уровнем холестерина после 40 лет неукоснительно, нужно сдать анализы на сахар в крови (глюкозу), выяснить, не превышена ли норма сахара по возрасту.
Расшифровка липидограммы
Случается что пациенту, которому назначают анализы, и он видит в своем бланке непонятное слово липидограмма. Выясним, что это такое и кому назначают анализ на липидограмму.
- Липидограмма – это тест на липидный спектр.
- Является дополнительным диагностическим тестом призванным помочь лечащему врачу узнать о состоянии, прежде всего печени, а так же почек, сердца, функционирование вашей иммунной системы.
- Липидный анализ состоит:
- общего холестерина,
- Липидов высокой плотности,
- низкой плотности,
- Уровень триглицеридов,
- индекс атерогенности.
Что такое коэффициент атерогенности
- Индекс атерогенности выявляет различие между уровнем ЛПНП и ЛПВП.
- Этот тест назначают, прежде всего, людям, у которых высокий риск развития инфаркта миокарда, инсульта.
- При изменении пропорций ЛПНП и ЛПВП симптомы заболевания могут отсутствовать, поэтому этот анализ очень важен с профилактической точки зрения.
- Назначают биохимический анализ на липидный спектр так же следующим пациентам:
- Находящимся на диете с ограничением жиров
- Принимающие лекарственные препараты, влияющие на липидный обмен
У только родившихся детей этот уровень не превышает 3,0 ммоль/л.
Затем этот показатель растет в зависимости от возраста и пола пациента.
У женщин индекс атерогенности может достигать высокого уровня во время климакса после прекращения действия женских гормонов, хотя до этого растем медленнее, чем у мужчин.
холестерина в крови зависимости от пола может быть от 3,6 ммоль/л до 7,8 ммоль/л.
| Холестерины | нормы |
| Общ. холестерин | до 5 ммоль/л |
| ЛПНП норма | до 3 ммоль/л |
| ЛПВП норма в крови | до 1 ммоль/л |
| триглицериды | до 2 ммоль/л |
Более 6 ммоль/л, тревожный показатель развития бляшек на сосудах. Хотя норма зависит от многих факторов, принято считать, что она не должна превышать более 5 ммоль/л. Беременные молодые женщины могут не беспокоиться по этому поводу, у них допускается некоторое увеличение от среднего уровня.
Важно обращать внимание на норму липопротеидов низкой плотности.
Какого-то точного показателя жиров низкой плотности нет, но показатель должен быть не более 2,5 ммоль.
Если превышен, то пересмотрите свое питание и образ жизни. Люди, находящиеся в группе риска, сердечно сосудистыми заболеваниями, инсультами — это показатель не должен превышать 1,6 ммоль.
Формула для вычисления Индекса атерогенности
- КА = (общ. холестерин – ЛПВП) / ЛПВП
- Нормальные показатели индекса атерогенности: у молодых допустимая норма – около 2,8; остальным людям, кому за 30 – 3-3,5;
- Пациентов предрасположенных к развитию атеросклероза и острой форме, коэффициент варьируется от 4 до 7 единиц.
Норма триглицеридов
Величина уровня глицерина и его производных зависит от возраста пациента.
До последнего времени это показатель был в районе 1,7 до 2,26 ммоль/л, для людей с риском сердечно сосудистых болезней это было нормой. Сейчас вероятность атеросклероза и инфаркта может быть при 1,13 ммоль/л
- У мужчин 25-30 лет — 0,52-2,81
- Женщин 25-30 лет — 0,42-1,63
Причины, когда понижен уровень триглециридов может быть:
- Болезни печени
- Легких
- Сахарный диабет
- Гипертония
- Гепатиты
- Цирроз печени
Повышенный триглециридов уровень при:
- Ишемической болезни сердца.
Норма холестерина для женщин по возрасту
Норма холестерина у женщин по возрасту в крови изменяется в период климакса, когда идет активная перестройка организма, до этого процесса уровень хлестерина, как правило, стабилен на протяжении всего периода жизни женщин.
В этот период отмечается повышенный холестерина у женщин. Не редки случаи, когда неопытный врач не точно оценивал результат анализов, что приводило к неправильному диагнозу.
На результат анализов, на холестерин может влиять не только пол пациента, возраст, но и ряд других условий и факторов.
Беременность – является очень значительным фактором повышение холестерин. В этот период происходит активный синтез жиров. Нормой холестерина в крови у беременных женщин является повышение не более чем на 12 – 15%.
Климакс – еще один из факторов
До 10% может повышаться холестерин в первую половину цикла, что не является отклонением.
Это физиологическая норма, позднее может доходить до 6-8%, что обусловлено перестройкой гормональной системы и синтезом жировых соединений.
Уменьщение выработки гормонов эстрогенов в климактерическом периоде у женщин может начаться стремительное прогрессирование атеросклероза. Однако после 60 лет риск заболевания атеросклерозом у обоих полов уравнивается.
Сезонные колебания
Физиологической нормой допускают отклонение на 2-4 % во время холодов, осени и зимы. Уровень может повышаться и понижаться.
Рак
Характеризуется значительным понижением уровня жирных спиртов. Объясняется это ростом раковой опухоли усилено потребляющей питательные вещества, а также жирного спирта.
Различные болезни
Некоторые заболевания значительно снижают концентрацию холестерина. Это могут быть болезни: стенокардия, острая артериальная гипертензия, ОРЗ. Результат их воздействия сохраняется от суток до 30 дней, но в некоторых случаях и больше. Понижение составляет не более 15-13%.
Лекарства
Некоторые лекарства могут, приводит к нарушению синтеза холестерина (ЛПВП). К ним относятся такие препараты как: оральные контрацептивы, бета-блокаторы, стероидные гормональные препараты, диуретики.
Суточная норма в холестерина
Ученые подсчитали, что для полноценной работы органов и систем жизнеобеспечения суточное количество холестерина должно составлять 1000 мг. Из них 800 мг вырабатывает печень. Остальное количество поступает с едой, дополняя запасы организма. Однако если «съедать» больше нормы, то будет уменьшаться синтез холестерола и желчных кислот печенью.
Норма холестерина у женщин по возрасту в таблице.
Норма холестерина возрасту от 40 до 50 лет.
Норма холестерина в крови у женщин после 40 лет– 45 лет:
- Норма общего холестерина у женщин 40 лет— 3.81-6.53 ммоль/л,
Холестерин норма у женщин по возрасту: таблица для 40 — 50 — 60 лет
Клеточные мембраны каждого человека содержат холестерин — органическое соединение, вырабатываемое организмом из употребляемой им пищи. Избыток холестериновых соединений в крови грозит развитием сердечно-сосудистых заболеваний. Правильно организовать питание и избежать проблем со здоровьем поможет таблица нормы холестерина у женщин по возрасту, составленная нашими экспертами.
От чего повышается холестерин в крови у женщин?
Холестерин представляет собой белое жироподобное вещество из группы липидов, без которого большинство физиологических процессов в организме человека было бы невозможным. Большая часть холестериновых соединений производится в печени, почках и кишечнике, еще некоторое количество поступает с пищей.
Стабильно поддерживаемая норма холестерина в крови отвечает за:
- формирование и поддержку клеточного каркаса;
- выработку стероидных гормонов;
- функциональность слизистой кишечника;
- производство витамина D.
Поскольку холестерин, являясь воскоподобным веществом, не растворяется в воде, его распространение по организму обеспечивают липопротеиды — белки, соединение с которыми образует растворимые формы.
По степени плотности эти комплексные соединения отличаются. Высокомолекулярные липопротеины плазмы крови характеризуются высокой плотностью, сокращенно ЛПВП, и известны, как «хороший» холестерин, поскольку предупреждают развитие и последствия атеросклероза.
Низкомолекулярные и очень низкомолекулярные (ЛПНП и ЛПОНП, соответственно) липопротеины носят название «плохого» холестерина, так как способствуют оседанию и накоплению холестериновых бляшек на стенках сосудов и постепенному закупориванию артерий.
Превышение нормы холестерина в течение 10 лет неизбежно приводит к патологиям сосудов и сердечным приступам.
Основные причины высокого уровня холестерина
В силу физиологических особенностей организма, женщины чаще мужчин страдают от последствий повышения холестерина.
Так происходит потому, что баланс липидов зависит от гормонального уровня в организме. А у женщин количество гормонов в крови изменяется в течение всей жизни — сначала в период беременности, затем при наступлении менопаузы.
Гормональные перестройки, сопровождающие самые важные периоды в организме женщины, отличаются нестабильностью выработки гормонов — в период беременности их количество резко увеличивается, а в период менопаузы стремительно падает.
И если в организме беременных огромное количество холестерина расходуется на производство гормонов, необходимых для нормального развития плода, то с появлением возрастных факторов липидные соединения остаются невостребованными, в силу резкого снижения уровня гормонального фона.
В числе других факторов, провоцирующих воспаление стенок сосудов и таким образом повышающих их уязвимость холестериновыми отложениями, относятся:
- лишний вес;
- злоупотребление алкогольными напитками;
- чрезмерное потребление продуктов, содержащих углеводы и насыщенные жиры;
- курение;
- низкая физическая активность;
- дисфункции внутренних органов — щитовидной железы, печени, надпочечников, поджелудочной железы;
- наследственная предрасположенность.
Как правило, рост уровня липидов в организме начинается после достижения женщиной 20-летнего возраста. Замедлить или даже остановить процесс накопления липопротеиновых веществ способна специальная диета при повышенном холестерине и регулярные физические нагрузки.
Норма холестерина для женщин по возрасту
Несоответствие холестеринового уровня норме негативно отражается на вязкости крови и прочности сосудов. Причем на здоровье женщины отрицательно влияет не только повышение, но и понижение показателей липидов.
Чтобы избежать возможного ухудшения самочувствия, необходимо периодически проверять показатели холестерина в организме и принимать соответствующие меры, если результаты исследования подтвердили наличие патологии. Специалисты рекомендуют проходить обследование каждые пять лет всем женщинами после достижения 20-лет.
С возрастом концентрация липопротеинов в крови увеличивается. Поэтому безопасный уровень холестериновых соединений в крови медики соотносят с возрастом.
У молодых женщин показатели липидов обычно низкие, поскольку интенсивность метаболических процессов позволяет справиться с вредными веществами даже при неправильном питании.
Норма холестерина по возрасту от 40 до 50-ти лет
После наступления 40-летнего возраста метаболизм замедляется, а состояние здоровья женщины изменяется в худшую сторону. Особенно, при наличии вредных привычек. Поэтому показатели нормы у сорокалетних выше, чем у тридцатилетних.
Для возраста 50 — 60 лет
У пятидесятилетних женщин наблюдается низкая проницаемость и эластичность сосудов, на фоне различных хронических заболеваний. Кроме того, в этот возрастной период происходит спад репродуктивной функции, а вместе с ним уменьшается количество эстрогенов — женских половых гормонов, стабилизирующих уровень липидов.
Соответственно и норма холестерин у женщин после 50 лет становится еще выше, чем прежде.
Норматив содержания холестерина после 60 лет
60-летний рубеж у женщин характеризуется наличием многих хронических заболеваний и наступлением менопаузы, повышающей концентрацию холестериновых соединений в крови. В этот период особенно важно постоянно контролировать уровень холестерина и сахара, а также правильно питаться.
После наступления 70 лет показатели нормы липидов существенно снижаются.
Верная таблица норм содержания холестерина по возрастуРасшифровка результата анализа крови на холестеринДиета при повышенном холестерине у женщинКак снизить холестерин народными средствами?
Поставьте лайк, если Вам понравился материал! Attuale — каждый день все самое актуальное!
Наш сайт — attuale.ru
показатель – это сумма значений ЛПНП и ЛПВП), можно увидеть, что диапазон холестериновой нормы изменяется с возрастом.
показатель – это сумма значений ЛПНП и ЛПВП), можно увидеть, что диапазон холестериновой нормы изменяется с возрастом. нормальным считается диапазон от 3,3 до 5,8 ммоль/л. В дальнейшем концентрация триглицеридов удваивается.
нормальным считается диапазон от 3,3 до 5,8 ммоль/л. В дальнейшем концентрация триглицеридов удваивается. ходьбе), онемение пальцев, изменение температуры конечностей и цвета кожных покровов.
ходьбе), онемение пальцев, изменение температуры конечностей и цвета кожных покровов.
 Рыбный жир
Рыбный жир  Имбирь Чеснок Корица Фреш Зеленый чай
Имбирь Чеснок Корица Фреш Зеленый чай